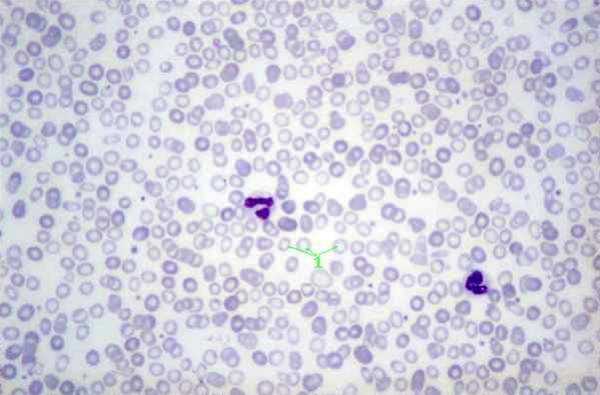
jernmangelanemi-celledyrkning

Jernmangelanæmi
Nedsat farvemætning af røde blodceller, som udviser forskellig form og størrelse (anisopoikilocytose)
Indhold leveret af
Patienthåndbogen
laegehaandbogen@dadl.dk
Patienthåndbogen
Kristianiagade 12
2100 København Ø
Disclaimer: Patienthåndbogen